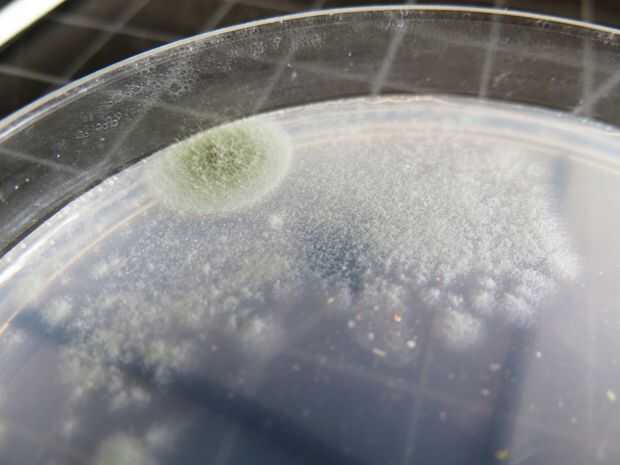

Paso 6: Bacterias TA-DAAAA!!! (y más)

Después de sólo un par de días, las colonias comenzará a crecer y crecer y crecer. De diversión para ver despegar el progreso de una colonia, y usted puede conseguir algunos

En cualquier esponja dado, usted puede obtener las bacterias, hongos o moldes (un tipo de hongos), que tienen un conjunto increíblemente diverso de características. Sería redondo, irregular, difusa, brillante o mate. Aquí es una gran guía partida para interpretar lo que has encontrado!
Esto es de cinco días después, y parece que nuestro asiento de tocador tenía algunas esporas de moho que están creciendo como locos en el cuadrante izquierdo. En cuanto a la boca de perro vs boca humana, voy a llamar un empate! Y la encimera de la cocina se ve bien!
Si miras muy cerca en sus colonias, se pueden ver cómo crecieron y las increíbles formas que toman como interactúan uno con el otro. Es una gran cosa para bosquejar y fotografiar con el tiempo, a medida que crece su imperio de granja mini. Cosas interesantes para seguir con los factores de la FDA para el crecimiento microbianoeste arranque en multiplicación de las bacteriasy están mirando la historia de los microorganismos de la comprensión.
Intente esto con las clases! Trate de cambiar la receta, el aplicador, el tiempo, la temperatura, todo! Su mundo es un experimento de ciencia esperando a suceder. Diviértete y sigue explorando.
Permítanme que crece!